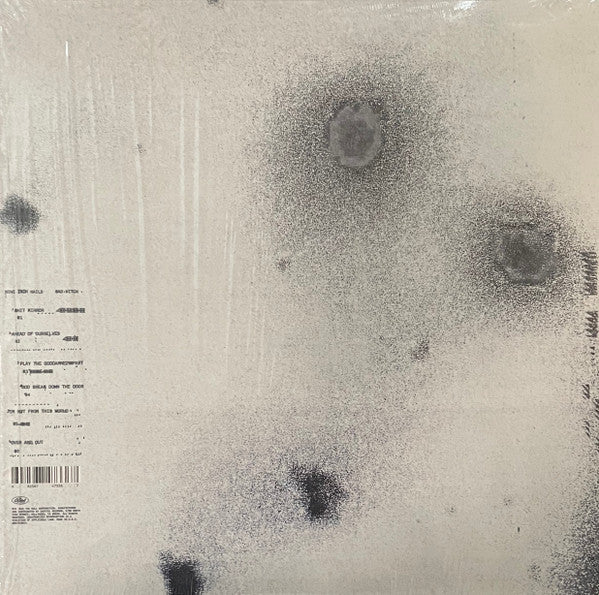
Nine Inch Nails ‎– Bad Witch

1
/
of
4
City Rat Records
Nine Inch Nails – Bad Witch
Nine Inch Nails – Bad Witch
Regular price
$25.00 USD
Regular price
Sale price
$25.00 USD
Unit price
/
per
Couldn't load pickup availability
Condition: New
Media: Mint (M)
Sleeve: Very Good Plus (VG+)
Notes: Reissue, 180 gram. Slight crease on top left front outer sleeve.
Tracklist
A1 Shit Mirror
Vocals [Additional Vocals] – Ian Astbury, Mariqueen Maandig Reznor
3:06
A2 Ahead Of Ourselves 3:31
A3 Play The Goddamned Part 4:50
B1 God Break Down The Door 4:16
B2 I'm Not From This World 6:42
B3 Over And Out 7:50
Vocals [Additional Vocals] – Ian Astbury, Mariqueen Maandig Reznor
3:06
A2 Ahead Of Ourselves 3:31
A3 Play The Goddamned Part 4:50
B1 God Break Down The Door 4:16
B2 I'm Not From This World 6:42
B3 Over And Out 7:50
Share